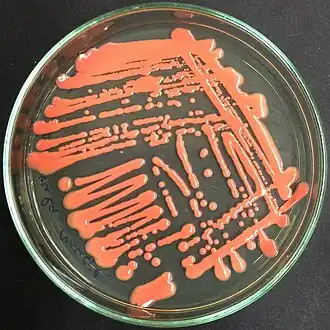

Rhodotorula
| Rhodotorula | ||||||||||||
|---|---|---|---|---|---|---|---|---|---|---|---|---|
Rhodotorula mucilaginosa | ||||||||||||
| Systematik | ||||||||||||
| ||||||||||||
| Wissenschaftlicher Name | ||||||||||||
| Rhodotorula | ||||||||||||
| F.C. Harrison |
Rhodotorula bilden eine Pilzgattung, die sich als Hefen durch Sprossung vermehren. Sie sind meist pigmentiert.
Merkmale
Makroskopische Merkmale
Rhodotorula-Kolonien sind schnellwachsend, glatt, glänzend oder matt, manchmal rau, weich und schleimig. Ihre Farbe variiert von cremefarben bis pink, korallenrot, orange oder gelb.[1][2]
Asexuelle Reproduktion
Die Blastokonidien sind subglobos, eiförmig, ellipsoid oder länglich. Die Reproduktion erfolgt durch multilaterale oder polare Knospung. Es können sowohl echte Hyphen oder auch Pseudohyphen gebildet werden, sie sind allerdings selten. Es sind keine Ballistokonidien bekannt. Viele Stämme haben rote oder gelbe Pigmente.[1]
Physiologische Merkmale
Rhodutorula-Arten besitzen nicht die Fähigkeit zur Fermentation. Alle Arten außer einigen Stämmen von Rhodutorula bacarum, Rhodutorula phylloplana und Rhodutorula yarrowii können auch nicht Myo-Inositol assimilieren. Stärkeähnliche Produkte werden nicht synthetisiert. Auf Anfärbung mit Echtblausalz B (Diazonium Blue B) reagieren Rhodutorula positiv und produzieren Urease. Coenzyme Q9 und Q10 sind vorhanden. In Zellhydrolysaten ist mit Ausnahme von Rhodutorula yarrowii keine Xylose vorhanden.[1][2]
Abgrenzung zu anderen Gattungen
Rhodotorula lässt sich von Cryptococcus dadurch unterscheiden, dass sie nicht Inositol assimilieren kann, von Candida durch ihr häufiges Fehlen von Pseudohyphen.[2]
Ökologie und Verbreitung
Rhodotorula-Arten sind weltweit in den unterschiedlichsten Lebensräumen verbreitet. Sie kommen in der Luft, im Boden, in Seen und Meeren vor. Sie wurden auch in Milchprodukten nachgewiesen. Sie besiedeln die Oberfläche von Pflanzen, Säugetieren und auch den Menschen.[1][2] Eine Art, Rhodotorula portillonensis, wurde kürzlich in Flachwassersedimenten der Antarktis entdeckt.[3] Sie kommen aber auch in ariden Gebieten vor.[4] Rhodotorula glutinis zeigt auch bei Temperaturen von −18 °C Wachstum.[5]
Rhodotorula benthica wurde aus Röhrenwürmern in der Tiefsee isoliert.[1] Rhodotorula svalbardensis wurde in einen Kryokonitloch in Spitzbergen gefunden.[6] Rhodotorula besiedelt oft die Oberfläche von Pflanzen. Sie kann dabei Lipide, Hemizellulose und stickstoffhaltige Stoffe aus ihrer Umwelt filtrieren. Manche Stämme können auch Ferulasäure, Hydroxyzimtsäuren, Gallussäure und Tannine assimilieren.[4][7] Rhodotorula mucilaginosa wurde sogar auf der International Space Station (ISS) nachgewiesen.[8] Dieser Pilz könnte zur Aufbereitigung von mit Eisen belasteten Wasser genutzt werden, da er dreiwertiges Eisen, Fe(III), akkumuliert.[9]
Systematik
Die systematische Stellung von Rhodotorula ist nach wie vor unklar. Die Gattung ist paraphyletisch. Der Großteil der Arten, nämlich 29, gehört zur Klasse der Microbotryomycetes aufgeteilt auf 2 Ordnungen, 14 Arten gehören zur Klasse der Cystobasidiomycetes, ebenfalls aufgeteilt in 2 Ordnungen und mehreren unsicheren Arten. Beide Klassen gehören zur Unterabteilung der Pucciniomycotina.[1][10] Die Typusart ist Rhodotorula glutinis.[1]
- Sporidiobolales
- Rhodotorula auriculariae
- Rhodotorula buffonii
- Rhodotorula cresolica
- Rhodotorula crocea
- Rhodotorula cycloclastica
- Rhodotorula diffluens
- Rhodotorula ferulica
- Rhodotorula foliorum
- Rhodotorula glutinis
- Rhodotorula hylophila
- Rhodotorula ingeniosa
- Rhodotorula javanica
- Rhodotorula lignophila
- Rhodotorula mucilaginosa
- Rhodotorula nothofagi
- Rhodotorula philyla
- Rhodotorula pilatii
- Rhodotorula pustula
- Rhodotorula retinophila
- Rhodotorula sonckii
- Rhodotorula terpenoidalis
- Rhodotorula vanillica
- Rhodotorula yarrowii
- Microbotryales
- Rhodotorula hordea
- Cystobasidiales
- Rhodotorula benthica
- Rhodotorula calyptogenae
- Rhodotorula laryngis
- Rhodotorula lysinophila
- Rhodotorula minuta
- Rhodotorula pallida
- Rhodotorula pinicola
- Rhodotorula slooffiae
- Erythrobasidiales
- Rhodotorula lactosa
- Aurantiaca-Gruppe:
- Rhodotorula armeniaca
- Rhodotorula aurantiaca
- Marina-Gruppe:
- Rhodotorula marina
- Sakaguchia-Gruppe:
- Rhodotorula lamellibrachiae
- Rhodotorula oryzae
Bedeutung
Rhodotorula-Arten treten nur selten als Humanpathogene in Erscheinung, sie können Mykosen und Fungämie in immunsupprimierten Patienten auslösen.[11] Auch Fälle von Meningitis, Endocarditis, Ventriculitis, Peritonitis, Endophthalmitis, Katheterinfektionen und Sepsis sind bekannt.[2]
Rhodotorula gracilis wird industriell für die Produktion von ß-Carotinoide genutzt.[12]
Belege
- ↑ a b c d e f g José Paulo Sampaio: Chapter 155: Rhodotorula, in: Cletus Kurtzman, J.W. Fell, Teun Boekhout (Hrsg.): „The Yeasts A Taxonomic Study, Volumen 1“; Elsevier, B.V. 2010: S. 1873 ff.; ISBN 978-0-444-52149-1. Online.
- ↑ a b c d e Dr. Fungus 2007. Rhodotorula spp. ( vom 14. April 2013 im Webarchiv archive.today) abgerufen am 11. Januar 2014
- ↑ Laich F., Vaca I., Chávez R. 2013. Rhodotorula portillonensis sp. nov., a basidiomycetous yeast isolated from Antarctic shallow-water marine sediment. International Journal of Systematic and Evolutionary Microbiology 63: 3884–3891 doi:10.1099/ijs.0.052753-0
- ↑ a b Middelhoven WJ. 1997. Identity and biodegradative abilities of yeasts isolated from plants growing in an arid climate. Antonie van Leeuwenhoek 72: 81–89. doi:10.1023/A:1000295822074
- ↑ Sven Piper: Exoplaneten. Die Suche nach einer zweiten Erde. Heidelberg 2014, S. 131.
- ↑ Purnima Singh, Shiv. M. Singh, Masaharu Tsuji, Gandham S. Prasad, Tamotsu Hoshinoc: Rhodotorula svalbardensis sp. nov., a novel yeast species isolated from cryoconite holes of Ny-Ålesund, Arctic. In: Cryobiology. Band 68, Ausgabe 1, Februar 2014, S. 122–128 doi:10.1016/j.cryobiol.2014.01.006.
- ↑ Sláviková, E., Vadkertiová, R. and Vránová, D. 2007. Yeasts colonizing the leaf surfaces. J. Basic Microbiol. 47: 344–350. doi:10.1002/jobm.200710310
- ↑ Aleksandra Checinska Sielaff, Camilla Urbaniak, Ganesh Babu Malli Mohan, Victor G. Stepanov, Quyen Tran, Jason M. Wood, Jeremiah Minich, Daniel McDonald, Teresa Mayer, Rob Knight, Fathi Karouia, George E. Fox and Kasthuri Venkateswaran 2019. Characterization of the total and viable bacterial and fungal communities associated with the International Space Station surfaces. Microbiome doi:10.1186/s40168-019-0666-x [1]
- ↑ A. Cudowski und A. Pietryczuk: Biochemical response of Rhodotorula mucilaginosa and Cladosporium herbarum isolated from aquatic environment on iron(iii) ions In: Scientific Reports, (2019) Band 9: 19492, Open Access doi:10.1038/s41598-019-56088-5
- ↑ Bauer R., Begerow D., Sampaio JP., Weiß M., Oberwinkler F. 2006. The simple-septate basidiomycetes: a synopsis. Mycol. Progr. 5: 41–66. doi:10.1007/s11557-006-0502-0
- ↑ Zaas AK, Boyce M, Schell W, Lodge BA, Miller JL, Perfect JR. 2003. Risk of fungemia due to Rhodotorula and antifungal susceptibility testing of Rhodotorula isolates. J Clin Microbiol. 41:5233–5235. PMC 262498 (freier Volltext) doi:10.1128/JCM.41.11.5233-5235.2003
- ↑ Vollrath Hopp: Chemische Kreisläufe in der Natur. Chemie - Biologie - Energetik (2018), Springer Spektrum Berlin, Heidelberg. ISBN 978-3-662-55860-7
